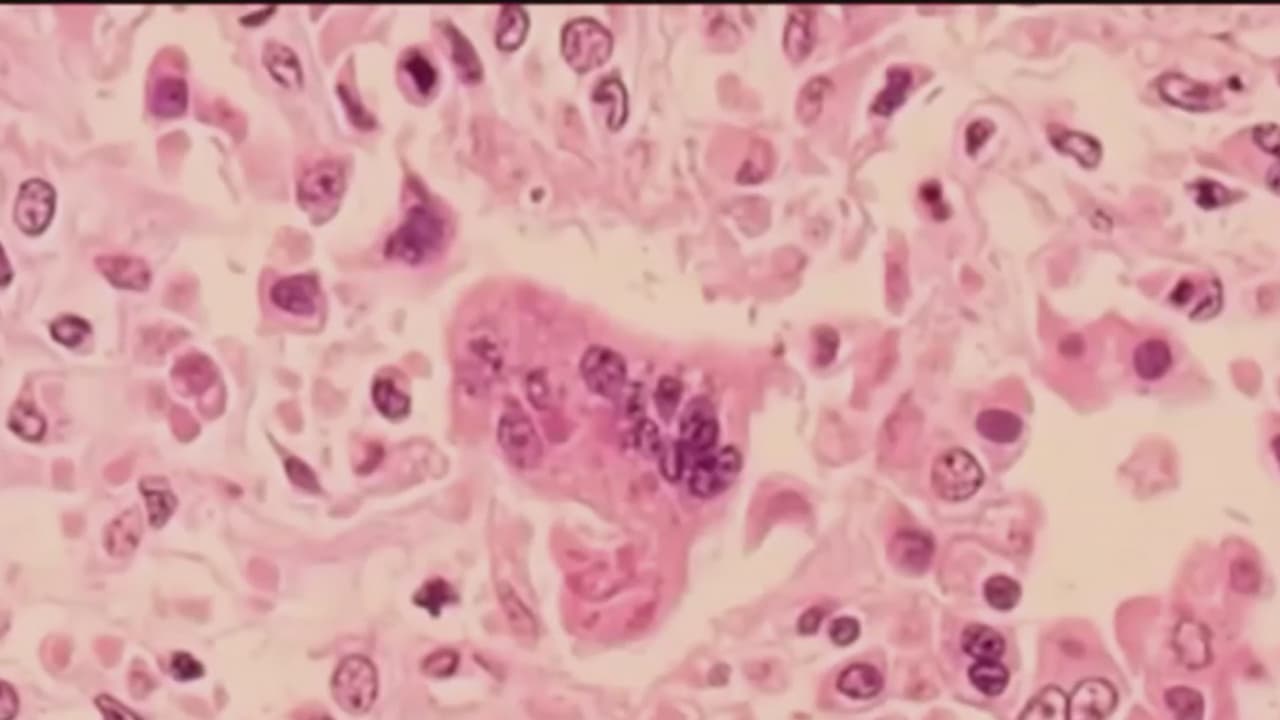

Lanzan alerta por posible infección de sarampión en una sala de cine en California
El departamento de salud pública reportó que una persona portadora de sarampión estuvo en una sala de cine en el condado Orange, por lo que es posible que quienes estaban allí hayan estado expuestos al virus.
Por:N+ Univision
Publicado el 2 may 19 - 01:11 PM EDT.